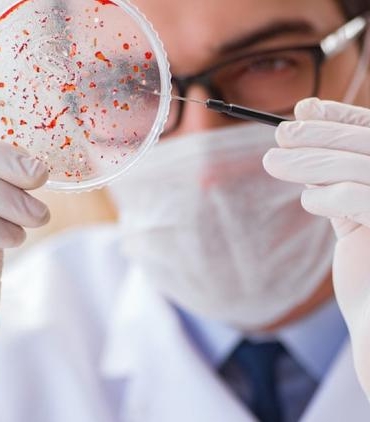
ispanyadaki-asf-salgini-gurcistan-susuna-yonelik-bulgular-ve-guvenlik-sorusturmasi-cyp5FW9M.jpg

1 Euro ne kadar? 1 Euro bugün kaç TL?
Güncel verilere göre, Euro alış fiyatı 53,42 TL, satış fiyatı ise 53,42 olarak belirlenmiştir. Bu fiyatlar, 26.05.2026 15:15:00 itibarıyla güncellenmiştir ve 15 dakikada bir yenilenerek canlı rakamlarla sunulmaktadır. Euro fiyatları hakkında anlık bilgilere erişmek için Euro sayfasını ziyaret edebilirsiniz.
Euro (TL) fiyatı bugün yükseldi.
Euro anlık olarak 53,42 TL fiyatından işlem görmektedir ve 24 saatlik yaklaşık işlem hacmi 0. Fiyatı son 24 saatte -0,060000 değişim göstermiştir..
Euro hesaplama işlemleri için, sayfanın üstünde yer alan çevirici aracını kullanarak mevcut fiyatlar üzerinden hızlı ve kolay bir şekilde çevirme işlemlerinizi gerçekleştirebilirsiniz. Euro fiyatları hakkında detaylı bilgi ve anlık güncellemeler için doğru adrestesiniz..
Daha Fazla